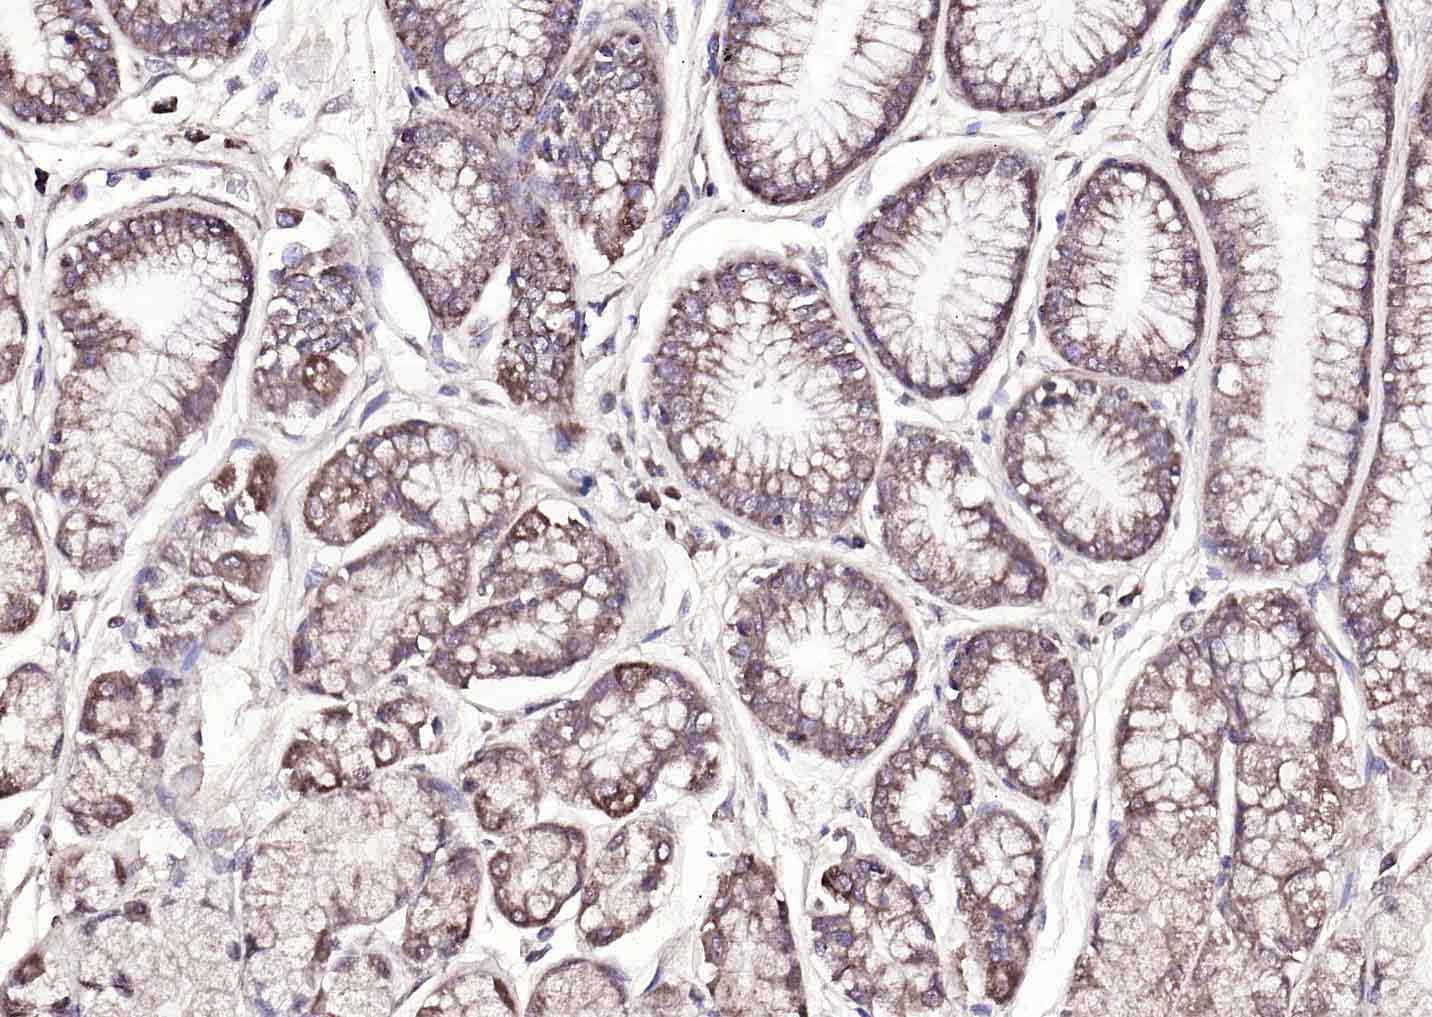
产品细节图片2

相关产品推荐更多 >

ADCY5 Rabbit pAb(bs-3922R)-50ul/100ul/200ul
¥1180
CD31 Recombinant Rabbit mAb(bsm-52428R)-50ul/100ul/25ul
¥800
C2orf63 Rabbit pAb, AP conjugated(bs-16119R-AP)-100ul
¥2980
Creatine kinase B type Rabbit pAb, RBITC conjugated(bs-11989R-RBITC)-100ul
¥2980
PCDH12 Rabbit pAb, BF488 conjugated(bs-11109R-BF488)-100ul
¥2980
万千商家帮你免费找货
0 人在求购买到急需产品
- 详细信息
- 文献和实验
- 技术资料
- 应用范围:
产品信息以Bioss网站为准
- 规格:
50ul/100ul/200ul
| 规格: | 50ul | 产品价格: | ¥1180.0 |
|---|---|---|---|
| 规格: | 100ul | 产品价格: | ¥1980.0 |
| 规格: | 200ul | 产品价格: | ¥2800.0 |
| 产品编号 | bs-3847R |
| 英文名称 | Amphiregulin Rabbit pAb |
| 中文名称 | 双调蛋白/结肠直肠细胞源性生长因子抗体 |
| 英文别名 | AR; Colorectum cell derived growth factor; CRDGF; A REG; AR antibody; AREG; Colorectum cell derived growth factor; CRDGF; MGC13647; Schwannoma derived growth factor; SDGF; AREG_HUMAN. |
| 产品应用 | WB=1:500-2000, IHC-P=1:100-500, IHC-F=1:100-500, IF=1:100-500 Not yet tested in other applications. |
| 交叉反应 | Human, Mouse, Rat (Dog, Cow, Horse, Rabbit, Sheep) |
| 抗体来源 | Rabbit |
| 免疫原 | KLH conjugated synthetic peptide derived from human Amphiregulin |
| 亚型 | IgG |
| 性状 | Liquid |
| 纯化方法 | affinity purified by Protein A |
| 克隆类型 | Polyclonal |
| 理论分子量 | 16 kDa |
| 浓度 | 1mg/ml |
| 储存液 | 0.01M TBS (pH7.4) with 1% BSA, 0.02% Proclin300 and 50% Glycerol. |
| 研究领域 | Cancer > Growth factors > EGF Signal Transduction > Growth Factors/Hormones > EGF |
| 亚基 | The immature precursor interacts with CNIH. |
| 亚细胞定位 | Membrane; Single-pass membrane protein. |
| 相似性 | Belongs to the amphiregulin family.
Contains 1 EGF-like domain. |
| 功能 | Ligand of the EGF receptor/EGFR. Autocrine growth factor as well as a mitogen for a broad range of target cells including astrocytes, Schwann cells and fibroblasts. |
| 保存条件 | Shipped at 4℃. Store at -20℃ for one year. Avoid repeated freeze/thaw cycles. |
| 注意事项 | This product as supplied is intended for research use only, not for use in human, therapeutic or diagnostic applications. |
| 背景资料 | Amphiregulin expression is induced by phorbol ester, estrogen, androgen, and other EGFR ligands. In vitro, amphiregulin functions as an autocrine growth stimulator to drive proliferation of colon carcinoma cells, normal and oncogene-transformed mammary epithelial cells, cervical carcinoma cells, prostate cancer cells, and keratinocytes. Amphiregulin is important in the development of human placenta and murine mammary gland. It is reportedly overexpressed in human cancers of breast, colon, stomach and pancreas. |
| 应用 | 推荐稀释比例 |
| {WB} | {1:500-2000} |
| {IHC-P} | {1:100-500} |
| {IHC-F} | {1:100-500} |
| {IF} | {1:100-500} |

HepG2(Human) Cell Lysate at 30 ug
Primary: Anti-Amphiregulin (bs-3847R) at 1/2000 dilution
Secondary: IRDye800CW Goat Anti-Rabbit IgG at 1/20000 dilution
Predicted band size: 26 kD
Observed band size: 41 kD

A549(Human) Cell Lysate at 30 ug
Primary: Anti-Amphiregulin (bs-3847R) at 1/500 dilution
Secondary: IRDye800CW Goat Anti-Rabbit IgG at 1/20000 dilution
Predicted band size: 26 kD
Observed band size: 41 kD


Antigen retrieval: citrate buffer ( 0.01M, pH 6.0 ), Boiling bathing for 15min; Blocking buffer (normal goat serum,C-0005) at 37℃ for 20 min;
Incubation: Anti-Amphiregulin Polyclonal Antibody, Unconjugated(bs-3847R) 1:200, overnight at 4°C; The secondary antibody was Goat Anti-Rabbit IgG, Cy3 conjugated(bs-0295G-Cy3)used at 1:200 dilution for 40 minutes at 37°C. DAPI(5ug/ml,blue,C-0033) was used to stain the cell nuclei

Antigen retrieval: citrate buffer ( 0.01M, pH 6.0 ), Boiling bathing for 15min; Blocking buffer (normal goat serum,C-0005) at 37℃ for 20 min;
Incubation: Anti-Amphiregulin Polyclonal Antibody, Unconjugated(bs-3847R) 1:200, overnight at 4°C; The secondary antibody was Goat Anti-Rabbit IgG, Cy3 conjugated(bs-0295G-Cy3)used at 1:200 dilution for 40 minutes at 37°C. DAPI(5ug/ml,blue,C-0033) was used to stain the cell nuclei

Antigen retrieval: citrate buffer ( 0.01M, pH 6.0 ), Boiling bathing for 15min; Blocking buffer (normal goat serum,C-0005) at 37℃ for 20 min;
Incubation: Anti-Amphiregulin Polyclonal Antibody, Unconjugated(bs-3847R) 1:200, overnight at 4°C; The secondary antibody was Goat Anti-Rabbit IgG, Cy3 conjugated(bs-0295G-Cy3)used at 1:200 dilution for 40 minutes at 37°C. DAPI(5ug/ml,blue,C-0033) was used to stain the cell nuclei

Lane 1: Mouse Placenta tissue lysates
Lane 2: Mouse Breast tissue lysates
Lane 3: Mouse Testis tissue lysates
Lane 4: Rat Placenta tissue lysates
Lane 5: Rat Breast tissue lysates
Lane 6: Rat Testis tissue lysates
Lane 7: Human MCF-7 cell lysates
Lane 8: Human HepG2 cell lysates
Lane 9: Human A431 cell lysates
Primary: Anti- Amphiregulin (bs-3847R) at 1/1000 dilution
Secondary: IRDye800CW Goat Anti-Rabbit IgG at 1/20000 dilution
Predicted band size: 16 kDa
Observed band size: 47 kDa
风险提示:丁香通仅作为第三方平台,为商家信息发布提供平台空间。用户咨询产品时请注意保护个人信息及财产安全,合理判断,谨慎选购商品,商家和用户对交易行为负责。对于医疗器械类产品,请先查证核实企业经营资质和医疗器械产品注册证情况。
文献和实验[IF={{ 8 }}] {Si-Ting Chen. et al. The activation of cGAS-STING pathway causes abnormal uterine receptivity in aged mice. AGING CELL. 2024 Aug;:e14303} {IF,WB} {Mouse}
[IF={{ 6.823 }}] {Bonnie Douglas. et al. Transgenic expression of a T cell epitope in Strongyloides ratti reveals that helminth-specific CD4+ T cells constitute both Th2 and Treg populations. Plos Pathog. 2021 Jul;17(7):e1009709} {IF} {Rat}
[IF={{ 6.684 }}] {Huihua Kai. et al. LncRNA NORAD Promotes Vascular Endothelial Cell Injury and Atherosclerosis Through Suppressing VEGF Gene Transcription via Enhancing H3K9 Deacetylation by Recruiting HDAC6. Front Cell Dev Biol. 2021; 9: 701628} {WB} {Human}
[IF={{ 5.192 }}] {Man She. et al. AREG is involved in scleral remodeling in form-deprivation myopia via the ERK1/2-MMP-2 pathway. FASEB J. 2022 May;36(5):e22289} {IF} {Pig}
[IF={{ 4.6 }}] {c "Evaluation of estrogenic potency of a standardized hops extract on mammary gland biology and on MNU-induced mammary tumor growth in rats." The Journal of Steroid Biochemistry and Molecular Biology (2017).} {IHC} {="Rat"}
= NAL), appears to form upon oxidative cyclization of the nonfluorescent 2:1 lysine-HNE Michael adduct-Schiff base cross-link (Scheme 1). Polyclonal antibody (PAb) to the NAL-HNE fluorophore was raised in rabbit and found to be highly specific
GE Healthcare Benzamidine Sepharose™ 6B is p-aminobenzamidine covalently attached to Sepharose 6B by the epoxy coupling method. p-Aminobenzamidine (PAB), is a synthetic inhibitor of trypsin-like serine protease. Trypsin and trypsin
T 1500/2500 进口分装 F0004 白细胞活化黏附因子(ALCAM) ELISA 48T/96T 2000/3000 进口分装 F0005 Amphiregulin ELISA 48T/96T 2000/3000 进口分装 F0006 血管紧张素I(ANG I) ELISA 48T/96T 2000/3000 进口分装 F0007 血管紧张素II(ANG II) ELISA 48T/96T 2000/3000 进口分装 F
技术资料暂无技术资料 索取技术资料





